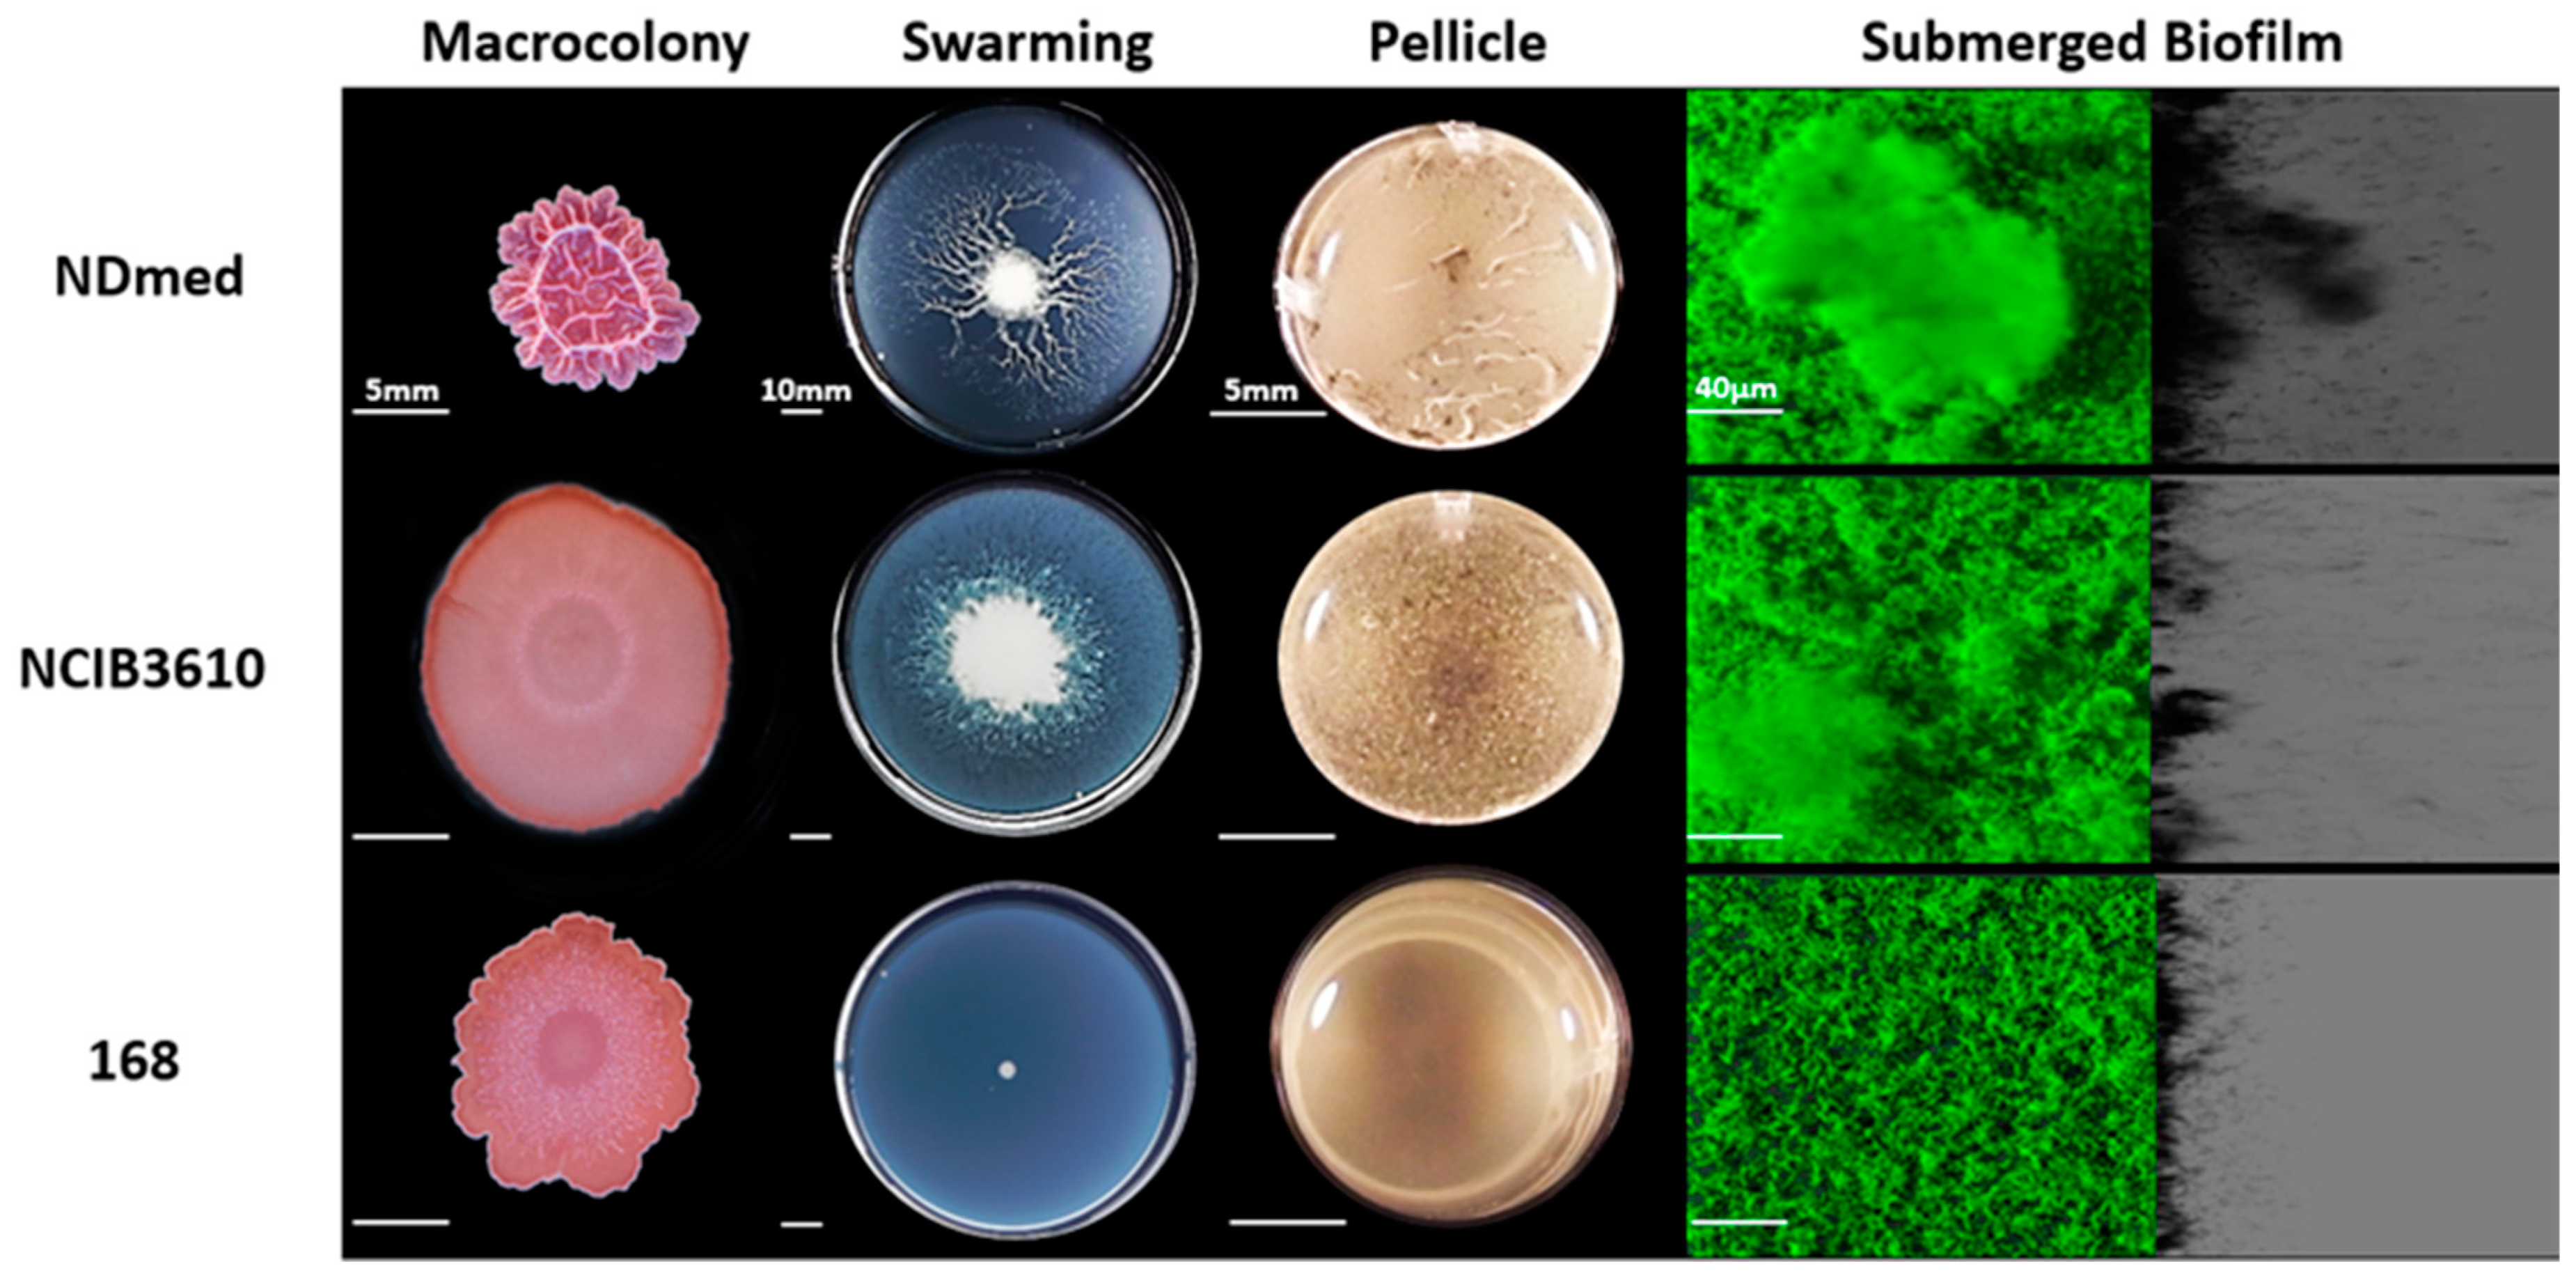
Microorganisms 09 00633 g001 Microorganisms 09 00633 g001

Comparison of the Genetic Features Involved in Bacillus subtilis Biofilm Formation Using Multi-Culturing Approaches
Abstract
1. Introduction
2. Materials and Methods
2.1. Bacterial Strains and Growth Conditions
| Strain | Genotype or Isolation Source | Construction a or Reference |
|---|---|---|
| NDmed | Undomesticated, isolated from endoscope washer-disinfectors | [31] |
| NCIB3610 | Natural isolate, less domesticated | [37] |
| 168 | trpC2 (domesticated strain) | [37] |
| GM3248 | NDmed ΔypqP:: kan | [13] |
| GM3533 | NDmed ΔsinR:: cm | Tf NDmed/DNA ABS840 [38] |
| GM3535 | NDmed ΔepsA-O:: tet | Tf NDmed/DNA GM3532 [NCIB3610, ΔtasA:: kan, ΔepsA-O:: tet] ( our lab collection) |
| GM3539 | NDmed ΔsinI:: kan | Tf NDmed/DNA ABS803 [39] |
| GM3545 | NDmed Δcap:: pKPSd/ cm | Tf NDmed/DNA GM3543 [NCIB3610 Δcap:: pKPSd/ cm] (our lab collection) |
| GM3555 | NDmed ΔabrB:: cm | Tf NDmed/DNA MM1717 [40] |
| GM3559 | NDmed ΔdegU:: neo | Tf NDmed/DNA GM719 [41] |
| GM3561 | NDmed ΔbslA:: cm | Tf NDmed/DNA NRS2097 [20] |
| GM3602 | NDmed ΔlytF:: spec | Tf NDmed/DNA NRS3295 [42] |
| GM3611 | NDmed ΔlytABC:: kan | Tf NDmed/DNA NRS3295 [42] |
| GM3614 | NDmed ΔtasA:: kan | Tf NDmed/DNA GM3532 [NCIB3610, ΔtasA:: kan, ΔepsA-O:: tet] ( our lab collection) |
| GM3618 | NDmed ΔslrR:: spec | Tf NDmed/DNA GM3598 [NCIB3610 ΔslrR:: spec] (our lab collection) |
| GM3619 | NDmed ΔsrfAA:: ery | Tf NDmed/DNA GM3599 [NCIB3610 ΔsrfAA:: ery] (our lab collection) |
| GM3652 | NDmed amyE:: Phyperspank-GFP/spec, Δhag::cm | Tf NDmedGFP [30]/DNA OMG954 [29] |
| GM3671 | NDmed amyE:: Phyperspank-GFP/spec, Δspo0A:: Kan | Tf NDmedGFP [30]/DNA FBT2 [43] |
2.2. Submerged Biofilm Developmental Assays
2.3. Macrocolony Experimental Conditions
2.4. Swarming Experiment Conditions
2.5. Pellicle Experiments
2.6. Non-Invasive Confocal Laser Scanning Microscopy (CLSM) of Submerged Biofilms
2.7. Statistical Analysis
3. Results and Discussion
3.1. Bacillus Subtilis NDmed forms Highly Structured Biofilms Compared to the NCIB3610 and 168 Strains
3.2. Mutants Affected in Matrix-Producing Components Fail to Form Well-Firmed Surface Cohesive Biofilms
3.3. Motility and Autolysins are Essentially Required for Architectural Submerged Biofilm Formation of B. subtilis NDmed
3.4. Mutation of B. subtilis NDmed Biofilm Regulators do Not Have the Same Impact on All Biofilm Models
4. Conclusions
Author Contributions
Funding
Data Availability Statement
Acknowledgments
Conflicts of Interest
References
- Shapiro, J.A. Thinking about bacterial populations as multicellular organisms. Annu. Rev. Microbiol. 1998, 52, 81–104. [Google Scholar] [CrossRef]
- Vlamakis, H.; Chai, Y.; Beauregard, P.B.; Losick, R.; Kolter, R. Sticking together: Building a biofilm the Bacillus subtilis way. Nat. Rev. Microbiol. 2013, 11, 157–168. [Google Scholar] [CrossRef]
- Kearns, D.B. A field guide to bacterial swarming motility. Nat. Rev. Microbiol. 2010, 8, 634–644. [Google Scholar] [CrossRef] [PubMed]
- Verstraeten, N.; Braeken, K.; Debkumari, B.; Fauvart, M.; Fransaer, J.; Vermant, J.; Michiels, J. Living on a surface: Swarming and biofilm formation. Trends Microbiol. 2008, 16, 496–506. [Google Scholar] [CrossRef] [PubMed]
- Lemon, K.P.; Earl, A.M.; Vlamakis, H.C.; Aguilar, C.; Kolter, R. Biofilm Development with an Emphasis on Bacillus subtilis. Curr. Top. Microbiol. Immunol. 2008, 322, 1–16. [Google Scholar] [CrossRef] [PubMed]
- Nagórska, K.; Bikowski, M.; Obuchowski, M. Multicellular behaviour and production of a wide variety of toxic substances support usage of Bacillus subtilis as a powerful biocontrol agent. Acta Biochim. Pol. 2007, 54, 495–508. [Google Scholar] [CrossRef]
- Jamal, M.; Ahmad, W.; Andleeb, S.; Jalil, F.; Imran, M.; Nawaz, M.A.; Hussain, T.; Ali, M.; Rafiq, M.; Kamil, M.A. Bacterial biofilm and associated infections. J. Chin. Med. Assoc. 2018, 81, 7–11. [Google Scholar] [CrossRef]
- Hamon, M.A.; Lazazzera, B.A. The sporulation transcription factor Spo0A is required for biofilm development in Bacillus subtilis. Mol. Microbiol. 2002, 42, 1199–1209. [Google Scholar] [CrossRef]
- Stanley, N.R.; Lazazzera, B.A. Defining the genetic differences between wild and domestic strains of Bacillus subtilis that affect poly-γ-dl-glutamic acid production and biofilm formation. Mol. Microbiol. 2005, 57, 1143–1158. [Google Scholar] [CrossRef] [PubMed]
- Kobayashi, K. Bacillus subtilis Pellicle Formation Proceeds through Genetically Defined Morphological Changes. J. Bacteriol. 2007, 189, 4920–4931. [Google Scholar] [CrossRef]
- Bridier, A.; Le Coq, D.; Dubois-Brissonnet, F.; Thomas, V.; Aymerich, S.; Briandet, R. The Spatial Architecture of Bacillus subtilis Biofilms Deciphered Using a Surface-Associated Model and In Situ Imaging. PLoS ONE 2011, 6, e16177. [Google Scholar] [CrossRef] [PubMed]
- Hamon, M.A.; Stanley, N.R.; Britton, R.A.; Grossman, A.D.; Lazazzera, B.A. Identification of AbrB-regulated genes involved in biofilmformation by Bacillus subtilis. Mol. Microbiol. 2004, 52, 847–860. [Google Scholar] [CrossRef] [PubMed]
- Sanchez-Vizuete, P.; Le Coq, D.; Bridier, A.; Herry, J.M.; Aymerich, S.; Briandet, R. Identification of ypqP as a new Bacillus subtilis biofilm determinant that mediates the protection of Staphylococcus aureus against antimicrobial agents in mixed-species communities. Appl. Environ. Microbiol. 2015, 81, 109–118. [Google Scholar] [CrossRef]
- Ostrov, I.; Sela, N.; Belausov, E.; Steinberg, D.; Shemesh, M. Adaptation of Bacillus species to dairy associated environment facilitates their biofilm forming ability. Food Microbiol. 2019, 82, 316–324. [Google Scholar] [CrossRef] [PubMed]
- Chu, F.; Kearns, D.B.; Branda, S.S.; Kolter, R.; Losick, R. Targets of the master regulator of biofilm formation in Bacillus subtilis. Mol. Microbiol. 2006, 59, 1216–1228. [Google Scholar] [CrossRef] [PubMed]
- Chai, Y.; Kolter, R.; Losick, R. Paralogous antirepressors acting on the master regulator for biofilm formation in Bacillus subtilis. Mol. Microbiol. 2009, 74, 876–887. [Google Scholar] [CrossRef]
- Kearns, D.B.; Chu, F.; Branda, S.S.; Kolter, R.; Losick, R. A master regulator for biofilm formation by Bacillus subtilis. Mol. Microbiol. 2004, 55, 739–749. [Google Scholar] [CrossRef]
- Kobayashi, K. SlrR/SlrA controls the initiation of biofilm formation in Bacillus subtilis. Mol. Microbiol. 2008, 69, 1399–1410. [Google Scholar] [CrossRef]
- Murray, E.J.; Kiley, T.B.; Stanley-Wall, N.R. A pivotal role for the response regulator DegU in controlling multicellular behaviour. Microbiology 2009, 155, 1–8. [Google Scholar] [CrossRef]
- Verhamme, D.T.; Murray, E.J.; Stanley-Wall, N.R. DegU and Spo0A Jointly Control Transcription of Two Loci Required for Complex Colony Development by Bacillus subtilis. J. Bacteriol. 2008, 191, 100–108. [Google Scholar] [CrossRef] [PubMed]
- Márquez-Magaña, L.M.; Chamberlin, M.J. Characterization of the sigD transcription unit of Bacillus subtilis. J. Bacteriol. 1994, 176, 2427–2434. [Google Scholar] [CrossRef] [PubMed]
- Marquez, L.M.; Helmann, J.D.; Ferrari, E.; Parker, H.M.; Ordal, G.W.; Chamberlin, M.J. Studies of σ(D)-dependent functions in Bacillus subtilis. J. Bacteriol. 1990, 172, 3435–3443. [Google Scholar] [CrossRef]
- Serizawa, M.; Yamamoto, H.; Yamaguchi, H.; Fujita, Y.; Kobayashi, K.; Ogasawara, N.; Sekiguchi, J. Systematic analysis of SigD-regulated genes in Bacillus subtilis by DNA microarray and Northern blotting analyses. Gene 2004, 329, 125–136. [Google Scholar] [CrossRef]
- Margot, P.; Pagni, M.; Karamata, D. Bacillus subtilis 168 gene lytF encodes a γ-d-glutamate-meso-diaminopimelate muropeptidase expressed by the alternative vegetative sigma factor, σD. Microbiology 1999, 145, 57–65. [Google Scholar] [CrossRef] [PubMed]
- Ostrowski, A.; Mehert, A.; Prescott, A.; Kiley, T.B.; Stanley-Wall, N.R. YuaB Functions Synergistically with the Exopolysaccharide and TasA Amyloid Fibers to Allow Biofilm Formation by Bacillus subtilis. J. Bacteriol. 2011, 193, 4821–4831. [Google Scholar] [CrossRef] [PubMed]
- Harshey, R.M. Bacterial Motility on a Surface: Many Ways to a Common Goal. Annu. Rev. Microbiol. 2003, 57, 249–273. [Google Scholar] [CrossRef] [PubMed]
- Julkowska, D.; Obuchowski, M.; Holland, I.B.; Séror, S.J. Comparative Analysis of the Development of Swarming Communities of Bacillus subtilis 168 and a Natural Wild Type: Critical Effects of Surfactin and the Composition of the Medium. Society 2005, 187, 65–76. [Google Scholar] [CrossRef]
- Julkowska, D.; Obuchowski, M.; Holland, I.B.; Séror, S.J. Branched swarming patterns on a synthetic medium formed by wild-type Bacillus subtilis strain 3610: Detection of different cellular morphologies and constellations of cells as the complex architecture develops. Microbiology 2004, 150, 1839–1849. [Google Scholar] [CrossRef]
- Hamze, K.; Julkowska, D.; Autret, S.; Hinc, K.; Nagorska, K.; Sekowska, A.; Holland, I.B.; Séror, S.J. Identification of genes required for different stages of dendritic swarming in Bacillus subtilis, with a novel role for phrC. Microbiology 2009, 155, 398–412. [Google Scholar] [CrossRef]
- Bridier, A.; Sanchez-Vizuete, M.d.P.; Le Coq, D.; Aymerich, S.; Meylheuc, T.; Maillard, J.-Y.; Thomas, V.; Dubois-Brissonnet, F.; Briandet, R. Biofilms of a Bacillus subtilis Hospital Isolate Protect Staphylococcus aureus from Biocide Action. PLoS ONE 2012, 7, e44506. [Google Scholar] [CrossRef]
- Martin, D.; Denyer, S.; McDonnell, G.; Maillard, J.-Y. Resistance and cross-resistance to oxidising agents of bacterial isolates from endoscope washer disinfectors. J. Hosp. Infect. 2008, 69, 377–383. [Google Scholar] [CrossRef]
- Abe, K.; Kawano, Y.; Iwamoto, K.; Arai, K.; Maruyama, Y.; Eichenberger, P.; Sato, T. Developmentally-Regulated Excision of the SPβ Prophage Reconstitutes a Gene Required for Spore Envelope Maturation in Bacillus subtilis. PLoS Genet. 2014, 10, e1004636. [Google Scholar] [CrossRef] [PubMed]
- Marmur, J. A procedure for the isolation of deoxyribonucleic acid from micro-organisms. J. Mol. Biol. 1961, 3, 208–218. [Google Scholar] [CrossRef]
- Anagnostopoulos, C.; Spizizen, J. Requirements for Transformation in Bacillus subtilis. J. Bacteriol. 1961, 81, 741–746. [Google Scholar] [CrossRef]
- Borenstein, S.; Ephrati-Elizur, E. Spontaneous release of DNA in sequential genetic order by Bacillus subtilis. J. Mol. Biol. 1969, 45, 137–152. [Google Scholar] [CrossRef]
- Antelmann, H.; Engelmann, S.; Schmid, R.; Sorokin, A.; Lapidus, A.; Hecker, M. Expression of a stress- and starvation-induced dps/pexB-homologous gene is controlled by the alternative sigma factor σ(B) in Bacillus subtilis. J. Bacteriol. 1997, 179, 7251–7256. [Google Scholar] [CrossRef] [PubMed]
- Zeigler, D.R.; Prágai, Z.; Rodriguez, S.; Chevreux, B.; Muffler, A.; Albert, T.; Bai, R.; Wyss, M.; Perkins, J.B. The Origins of 168, W23, and Other Bacillus subtilis Legacy Strains. J. Bacteriol. 2008, 190, 6983–6995. [Google Scholar] [CrossRef]
- Bidnenko, V.; Nicolas, P.; Grylak-Mielnicka, A.; Delumeau, O.; Auger, S.; Aucouturier, A.; Guérin, C.; Repoila, F.; Bardowski, J.; Aymerich, S.; et al. Termination factor Rho: From the control of pervasive transcription to cell fate determination in Bacillus subtilis. PLoS Genet. 2017, 13, e1006909. [Google Scholar] [CrossRef]
- Monteferrante, C.G.; MacKichan, C.; Marchadier, E.; Prejean, M.-V.; Van Dijl, J.M.; Carballido-López, R. Mapping the twin-arginine protein translocation network of Bacillus subtilis. Proteomics 2013, 13, 800–811. [Google Scholar] [CrossRef]
- Nagórska, K.; Hinc, K.; Strauch, M.A.; Obuchowski, M. Influence of the σB Stress Factor and yxaB, the Gene for a Putative Exopolysaccharide Synthase under σB Control, on Biofilm Formation. J. Bacteriol. 2008, 190, 3546–3556. [Google Scholar] [CrossRef] [PubMed]
- Crutz, A.M.; Steinmetz, M. Transcription of the Bacillus subtilis sacX and sacY genes, encoding regulators of sucrose metabolism, is both inducible by sucrose and controlled by the DegS-DegU signalling system. J. Bacteriol. 1992, 174, 6087–6095. [Google Scholar] [CrossRef] [PubMed]
- Murray, E.J.; Stanley-Wall, N.R. The sensitivity of Bacillus subtilis to diverse antimicrobial compounds is influenced by Abh. Arch. Microbiol. 2010, 192, 1059–1067. [Google Scholar] [CrossRef]
- Dervyn, E.; Poncet, S.; Klier, A.; Rapoport, G. Transcriptional regulation of the cryIVD gene operon from Bacillus thuringiensis subsp. israelensis. J. Bacteriol. 1995, 177, 2283–2291. [Google Scholar] [CrossRef] [PubMed]
- Bridier, A.; Dubois-Brissonnet, F.; Boubetra, A.; Thomas, V.; Briandet, R. The biofilm architecture of sixty opportunistic pathogens deciphered using a high throughput CLSM method. J. Microbiol. Methods 2010, 82, 64–70. [Google Scholar] [CrossRef] [PubMed]
- Friedman, L.; Kolter, R. Genes involved in matrix formation in Pseudomonas aeruginosa PA14 biofilms. Mol. Microbiol. 2003, 51, 675–690. [Google Scholar] [CrossRef]
- Romero, D.; Aguilar, C.; Losick, R.; Kolter, R. Amyloid fibers provide structural integrity to Bacillus subtilis biofilms. Proc. Natl. Acad. Sci. USA 2010, 107, 2230–2234. [Google Scholar] [CrossRef]
- Kiersztyn, B.; Siuda, W.; Chróst, R. Coomassie Blue G250 for Visualization of Active Bacteria from Lake Environment and Culture. Pol. J. Microbiol. 2017, 66, 365–373. [Google Scholar] [CrossRef]
- Neumann, U.; Khalaf, H.; Rimpler, M. Quantitation of electrophoretically separated proteins in the submicrogram range by dye elution. Electrophoresis 1994, 15, 916–921. [Google Scholar] [CrossRef]
- Branda, S.S.; González-Pastor, J.E.; Ben-Yehuda, S.; Losick, R.; Kolter, R. Fruiting body formation by Bacillus subtilis. Proc. Natl. Acad. Sci. USA 2001, 98, 11621–11626. [Google Scholar] [CrossRef] [PubMed]
- McLoon, A.L.; Guttenplan, S.B.; Kearns, D.B.; Kolter, R.; Losick, R. Tracing the Domestication of a Biofilm-Forming Bacterium. J. Bacteriol. 2011, 193, 2027–2034. [Google Scholar] [CrossRef]
- Branda, S.S.; González-Pastor, J.E.; Dervyn, E.; Ehrlich, S.D.; Losick, R.; Kolter, R. Genes Involved in Formation of Structured Multicellular Communities by Bacillus subtilis. J. Bacteriol. 2004, 186, 3970–3979. [Google Scholar] [CrossRef] [PubMed]
- Branda, S.S.; Chu, F.; Kearns, D.B.; Losick, R.; Kolter, R. A major protein component of the Bacillus subtilis biofilm matrix. Mol. Microbiol. 2006, 59, 1229–1238. [Google Scholar] [CrossRef] [PubMed]
- Kobayashi, K.; Iwano, M. BslA(YuaB) forms a hydrophobic layer on the surface of Bacillus subtilis biofilms. Mol. Microbiol. 2012, 85, 51–66. [Google Scholar] [CrossRef]
- Kobayashi, K. Gradual activation of the response regulator DegU controls serial expression of genes for flagellum formation and biofilm formation in Bacillus subtilis. Mol. Microbiol. 2007, 66, 395–409. [Google Scholar] [CrossRef] [PubMed]
- Yu, Y.; Yan, F.; Chen, Y.; Jin, C.; Guo, J.-H.; Chai, Y. Poly-γ-Glutamic Acids Contribute to Biofilm Formation and Plant Root Colonization in Selected Environmental Isolates of Bacillus subtilis. Front. Microbiol. 2016, 7, 1811. [Google Scholar] [CrossRef]
- Kearns, D.B.; Losick, R. Cell population heterogeneity during growth of Bacillus subtilis. Genes Dev. 2005, 19, 3083–3094. [Google Scholar] [CrossRef] [PubMed]
- Houry, A.; Gohar, M.; Deschamps, J.; Tischenko, E.; Aymerich, S.; Gruss, A.; Briandet, R. Bacterial swimmers that infiltrate and take over the biofilm matrix. Proc. Natl. Acad. Sci. USA 2012, 109, 13088–13093. [Google Scholar] [CrossRef]
- Hölscher, T.; Bartels, B.; Lin, Y.-C.; Gallegos-Monterrosa, R.; Price-Whelan, A.; Kolter, R.; Dietrich, L.E.P.; Kovács, Á.T. Motility, Chemotaxis and Aerotaxis Contribute to Competitiveness during Bacterial Pellicle Biofilm Development. J. Mol. Biol. 2015, 427, 3695–3708. [Google Scholar] [CrossRef]
- Chen, R.; Guttenplan, S.B.; Blair, K.M.; Kearns, D.B. Role of the σD-dependent autolysins in Bacillus subtilis population heterogeneity. J. Bacteriol. 2009, 191, 5775–5784. [Google Scholar] [CrossRef]
- Smith, T.J.; Foster, S.J. Characterization of the involvement of two compensatory autolysins in mother cell lysis during sporulation of Bacillus subtilis 168. J. Bacteriol. 1995, 177, 3855–3862. [Google Scholar] [CrossRef]
- Kearns, D.B.; Chu, F.; Rudner, R.; Losick, R. Genes governing swarming in Bacillus subtilis and evidence for a phase variation mechanism controlling surface motility. Mol. Microbiol. 2004, 52, 357–369. [Google Scholar] [CrossRef] [PubMed]
- Verhamme, D.T.; Kiley, T.B.; Stanley-Wall, N.R. DegU co-ordinates multicellular behaviour exhibited by Bacillus subtilis. Mol. Microbiol. 2007, 65, 554–568. [Google Scholar] [CrossRef] [PubMed]
- Mielich-süss, B.; Lopez, D. Molecular mechanisms involved in Bacillus subtilis biofilm formation. Environ. Microbiol. 2015, 17, 555–565. [Google Scholar] [CrossRef] [PubMed]
- Strauch, M.; Webb, V.; Spiegelman, G.; Hoch, J.A. The Spo0A protein of Bacillus subtilis is a repressor of the abrB gene. Proc. Natl. Acad. Sci. USA 1990, 87, 1801–1805. [Google Scholar] [CrossRef] [PubMed]
- Takada, H.; Morita, M.; Shiwa, Y.; Sugimoto, R.; Suzuki, S.; Kawamura, F.; Yoshikawa, H. Cell motility and biofilm formation in Bacillus subtilis are affected by the ribosomal proteins, S11 and S21. Biosci. Biotechnol. Biochem. 2014, 78, 898–907. [Google Scholar] [CrossRef]
- Chu, F.; Kearns, D.B.; McLoon, A.; Chai, Y.; Kolter, R.; Losick, R. A novel regulatory protein governing biofilm formation in Bacillus subtilis. Mol. Microbiol. 2008, 68, 1117–1127. [Google Scholar] [CrossRef]
- Chai, Y.; Kolter, R.; Losick, R. Reversal of an epigenetic switch governing cell chaining in Bacillus subtilis by protein instability. Mol. Microbiol. 2010, 78, 218–229. [Google Scholar] [CrossRef]
- Copeland, M.F.; Weibel, D.B. Bacterial swarming: A model system for studying dynamic self-assembly. Soft Matter 2009, 5, 1174–1187. [Google Scholar] [CrossRef] [PubMed]

Publisher’s Note: MDPI stays neutral with regard to jurisdictional claims in published maps and institutional affiliations. |
© 2021 by the authors. Licensee MDPI, Basel, Switzerland. This article is an open access article distributed under the terms and conditions of the Creative Commons Attribution (CC BY) license (http://creativecommons.org/licenses/by/4.0/).
Share and Cite
Dergham, Y.; Sanchez-Vizuete, P.; Le Coq, D.; Deschamps, J.; Bridier, A.; Hamze, K.; Briandet, R. Comparison of the Genetic Features Involved in Bacillus subtilis Biofilm Formation Using Multi-Culturing Approaches. Microorganisms 2021, 9, 633. https://doi.org/10.3390/microorganisms9030633
Dergham Y, Sanchez-Vizuete P, Le Coq D, Deschamps J, Bridier A, Hamze K, Briandet R. Comparison of the Genetic Features Involved in Bacillus subtilis Biofilm Formation Using Multi-Culturing Approaches. Microorganisms. 2021; 9(3):633. https://doi.org/10.3390/microorganisms9030633
Chicago/Turabian StyleDergham, Yasmine, Pilar Sanchez-Vizuete, Dominique Le Coq, Julien Deschamps, Arnaud Bridier, Kassem Hamze, and Romain Briandet. 2021. "Comparison of the Genetic Features Involved in Bacillus subtilis Biofilm Formation Using Multi-Culturing Approaches" Microorganisms 9, no. 3: 633. https://doi.org/10.3390/microorganisms9030633
APA StyleDergham, Y., Sanchez-Vizuete, P., Le Coq, D., Deschamps, J., Bridier, A., Hamze, K., & Briandet, R. (2021). Comparison of the Genetic Features Involved in Bacillus subtilis Biofilm Formation Using Multi-Culturing Approaches. Microorganisms, 9(3), 633. https://doi.org/10.3390/microorganisms9030633

